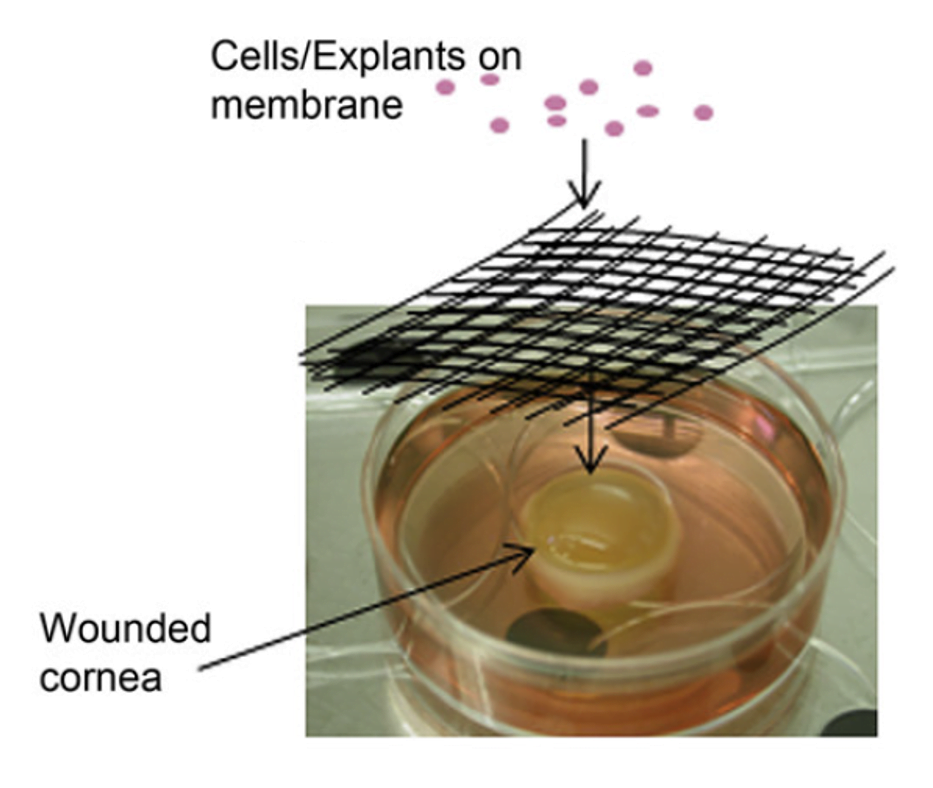

Cornea Regeneration on a Synthetic Membrane with Limbal Tissue Explants
The University of Sheffield, in collaboration with the L.V.Prasad eye clinic in Hyderabad, developed corneal repair materials and procedures that offer a step change in availability and affordability. Phase I clinical trials have demonstrated patient safety.

The Electrospinning Company supplied biodegradable synthetic membranes to a team, led by Professor Sheila MacNeil of the University of Sheffield, who were developing affordable corneal surface regeneration techniques in collaboration with Dr Virender Sangwan at the L.V.Prasad eye clinic in Hyderabad, India. The concept that a corneal epithelium can be regenerated on the eye with very small pieces of tissue has been demonstrated using human amniotic membrane (current state-of-the art). In this project, funded by the Wellcome Trust Affordable Healthcare for India programme, the Anglo-Indian team aimed to simplify this technique to make it available to ophthalmic surgeons worldwide. A synthetic sterilised biodegradable membrane was developed at Sheffield and evaluated in vitro. Safety was demonstrated in an in vivo model. A phase I clinical trial was conducted at the L.V. Prasad eye clinic in Hyderabad, India.
A publication in Biomaterials titled “Simplifying corneal surface regeneration using a biodegradable synthetic membrane and limbal tissue explants”, on which Dr Rob McKean is a co-author, describes how corneal cells have been successfully cultured on a synthetic sterilised biodegradable membrane either from cells isolated in a laboratory or from cells grown out from very small pieces of tissue. A second publication in the British Journal of Ophthalmology describes the pre-clinical tests that showed that membranes could be safely applied to rabbit eyes (the standard model) without inducing local or systemic toxicity and that the membranes broke down completely within 29 days.
Specialist stem cells at the front of the eye have the job of keeping the cornea clear and scar-free. If someone loses the population of cells that renew this corneal epithelium then surrounding scar type tissue grows over the eye with resulting loss of vision and pain. For some 15 years in a few specialist centres around the world it has been possible to take a small piece of tissue from the unaffected eye, expand these cells in a specialist laboratory and then transplant these back to the cornea, applying the cells to the damaged cornea on pieces of human donor amniotic membrane. This requires access to a well-run tissue bank to access the donor amniotic membrane, as well as access to clean rooms, specialist clean room staff to culture the cells and considerable surgical skill.
The Electrospinning Company manufactured clinical grade scaffolds with full Quality documentation and supported the regulatory submissions.
Source: P. Deshpande, C. Ramachandran, F. Sefat, I. Mariappan, C. Johnson, R. McKean, M. Hannah, V. S. Sangwan, F. Claeyssens, A. J. Ryand, S. MacNeil “Simplifying corneal surface regeneration using a biodegradable synthetic membrane and limbal tissue explants” Biomaterials 34, 21 (2013), pp. 5088–5106.
C Ramachandran, V Sangwan, I Ortega, U Bhatnagar, S Mulla, R McKean, S MacNeil, Synthetic biodegradable alternatives to the use of the amniotic membrane for corneal regeneration: assessment of local and systemic toxicity in rabbits </a>“.British journal of ophthalmology 2018


